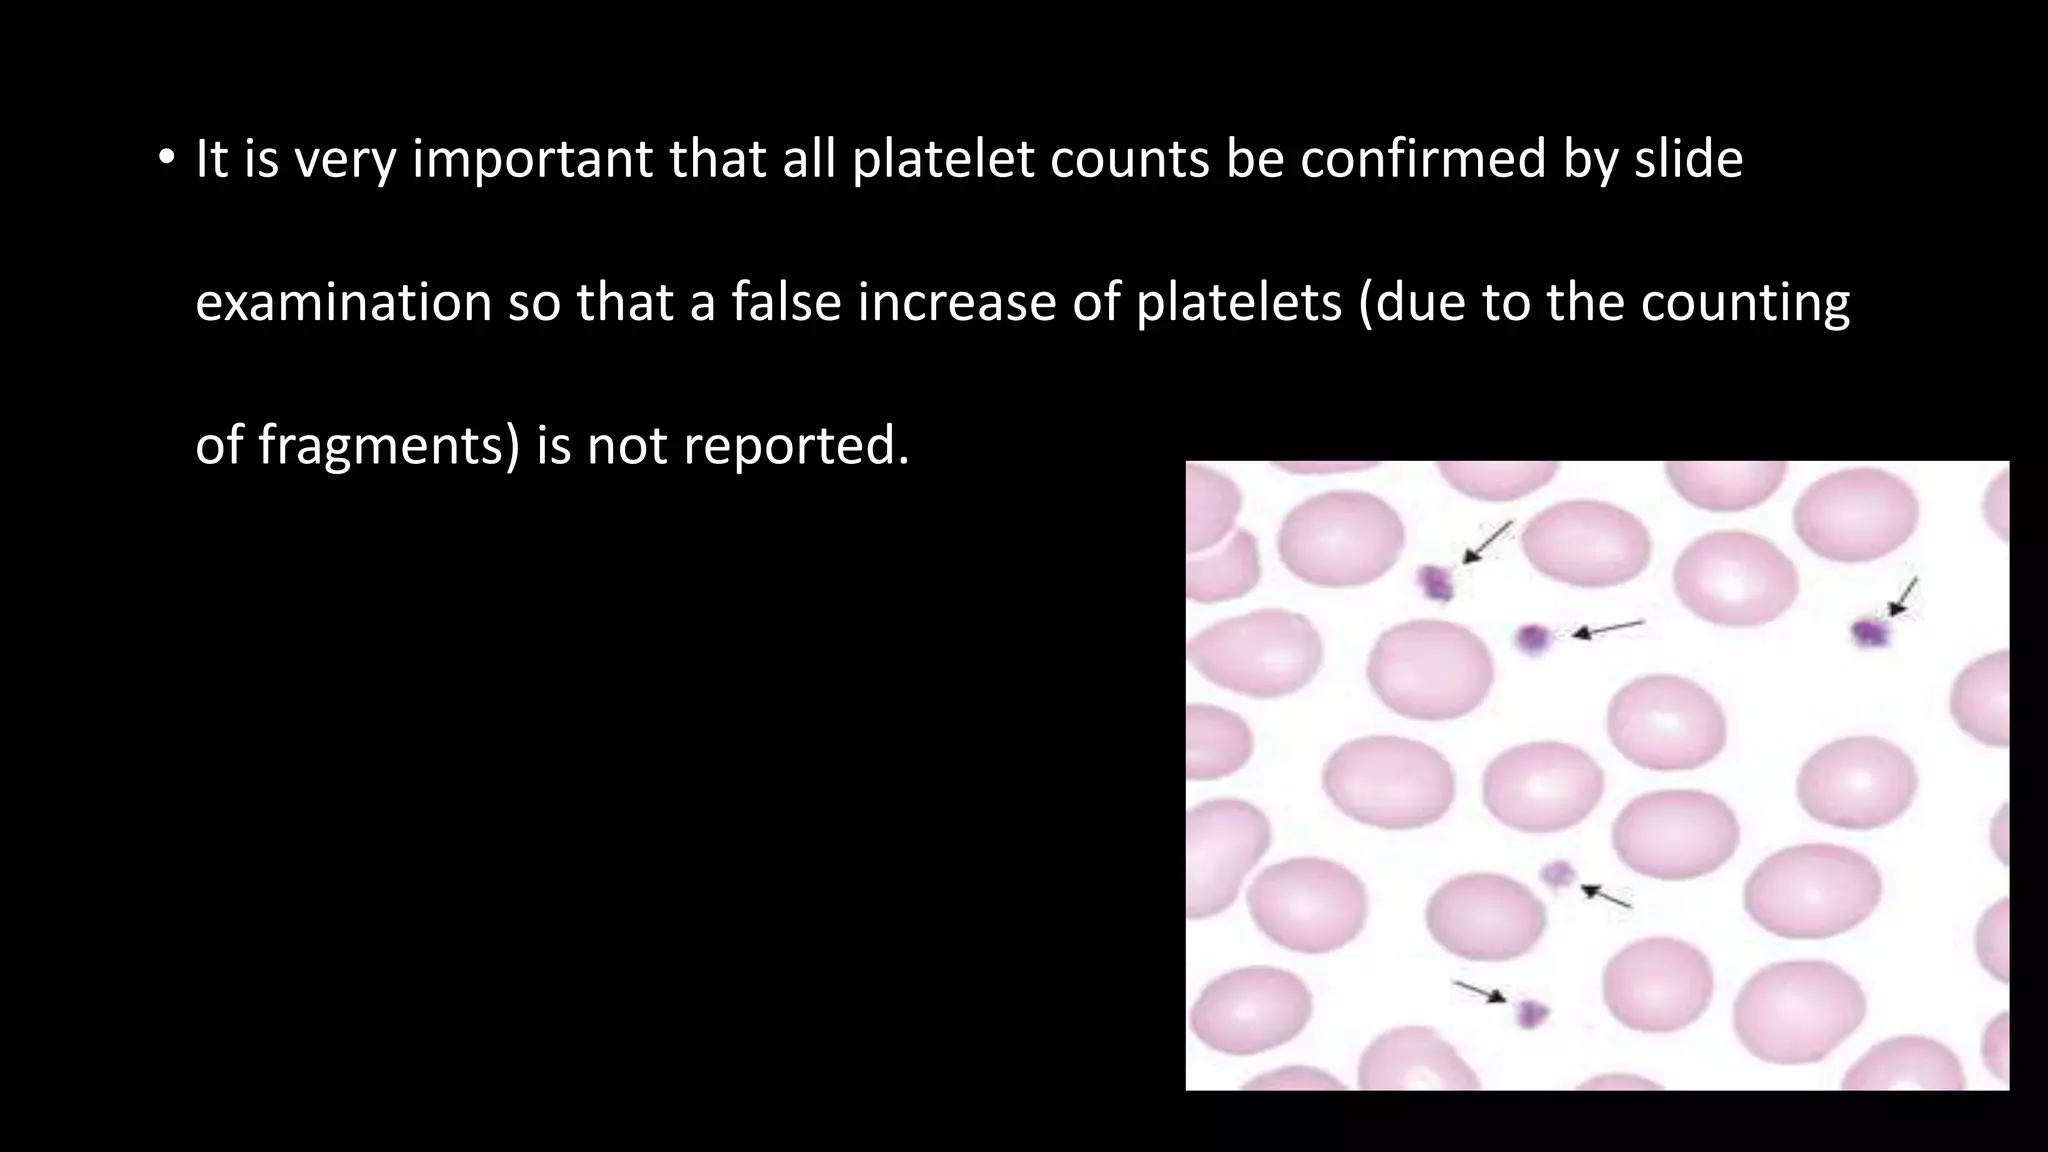
• It is very important that all platelet counts be confirmed by slide
examination so that a false increase of platelets (due to the counting
of fragments) is not reported.

This document describes the procedure for performing a total white blood cell count. It involves diluting a blood sample with a solution that lyses red blood cells and stains white blood cell nuclei. The diluted sample is then placed in a counting chamber and the number of white blood cells in a specific area are counted under a microscope. The total white blood cell count is then calculated based on the dilution factor and area counted. Normal ranges provided are 4-11 x 103 cells/μL or 4-11 x 109 cells/L. Abnormal values above or below this range would indicate leukocytosis or leukopenia, respectively. Potential sources of error are also noted but not described.